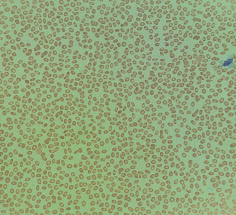

Les elliptocytes et les ovalocytes
Les elliptocytes et les ovalocytes sont des globules rouges dont la forme est allongée. Il faut noter qu'il existe deux conventions contradictoires sur l'usage de ces deux termes: certains laboratoires les utilisent comme des synonymes, tandis qu'il est plus courant de les voir désigner deux types de géométrie:
Les ovalocytes seront plutôt des cellules légèrement allongées mais globalement arrondies, en forme d'oeuf.
Les elliptocytes réfèrent de leur côté à des cellules très étirées, en forme de cigare.
Une légère elliptocytose est normale et n'est pas à signaler. Elle résulte du vieillissement normal des globules rouges, dont le cytosquelette ne reprend plus aussi bien sa forme originale après s'être comprimé pour passer dans les capillaires.
Les causes de l'elliptocytose sont multiples:
- Elliptocytose héréditaire: caractérisée par un très grand nombre d'elliptocytes, affectant la majorité ou même la totalité des globules rouges observés. Elle provient d'une mutation de la spectrine, une protéine de la membrane, qui modifie son élasticité. Les cellules naissent avec une forme normale, mais sont immédiatement modifiées par leur passage dans les capillaires et ne la reprennent plus. Ces cellules sont reconnues comme vieilles et endommagées dans la rate et éliminées prématurément, ce qui peut mener à une anémie hémolytique.
- Thalassémie et anémie ferriprive: les globules rouges qui ont un contenu diminué en hémoglobine sont plus susceptibles aux déformations. Les cellules sont petites et pâles, on verra fréquemment des codocytes et une poïkilocytose en général.
- Drépanocytose: la membrane des drépanocytes a une constitution normale, mais la déformation de la cellule causée par un épisode de falciformation excède son élasticité et provoque des déformations permanentes. Les elliptocytes peuvent être accompagnés de drépanocytes ou se présenter seuls, si la maladie est en latence. Ils sont généralement plus irréguliers que les elliptocytes formés par les autres mécanismes.
L'ovalocytose a aussi quelques causes possibles:
- Ovalocytose héréditaire: très semblable à l'elliptocytose héréditaire, mais moins sévère, conduisant moins souvent à un trouble hémolytique. Cette variante est aussi beaucoup plus rare.
- Anémie mégaloblastique: un déficit en vitamine B12 perturbe la division des cellules et provoque un asynchronisme de maturation entre le cytoplasme et le noyau. Toutes les cellules du corps sont affectés par cette carence, mais chez le globule rouge, elle se manifeste par des mégaloblastes, des globules rouges géants dont la forme est souvent ovale.
- Malaria: le parasite Plasmodium ovale provoque une ovalisation des cellules infectées. On ne risque pas de confondre cette morphologie avec une autre, puisque le parasite sera nettement visible dans la cellule.
Les traitements:
Selon la cause de l'elliptocytose, le traitement peut soit cibler l'agent causal, soit les symptômes:
Les carences en fer ou en vitamines doivent être corrigées. Les elliptocytes et autres poïkilocites en circulation resteront anormales pour le reste de leur durée de vie, mais les nouvelles hématies produites seront normales. On s'attend donc à découvrir une double population sur les frottis suivant.
Les troubles héréditaires ne peuvent pas être corrigés, on ciblera plutôt leurs effets. La splénectomie prolonge la durée de vie des globules rouges anormaux en ralentissant leur élimination. Des cas sévères peuvent exiger des transfusions, mais on devra se méfier du risque de surcharge en fer.

Commentaires
Enregistrer un commentaire